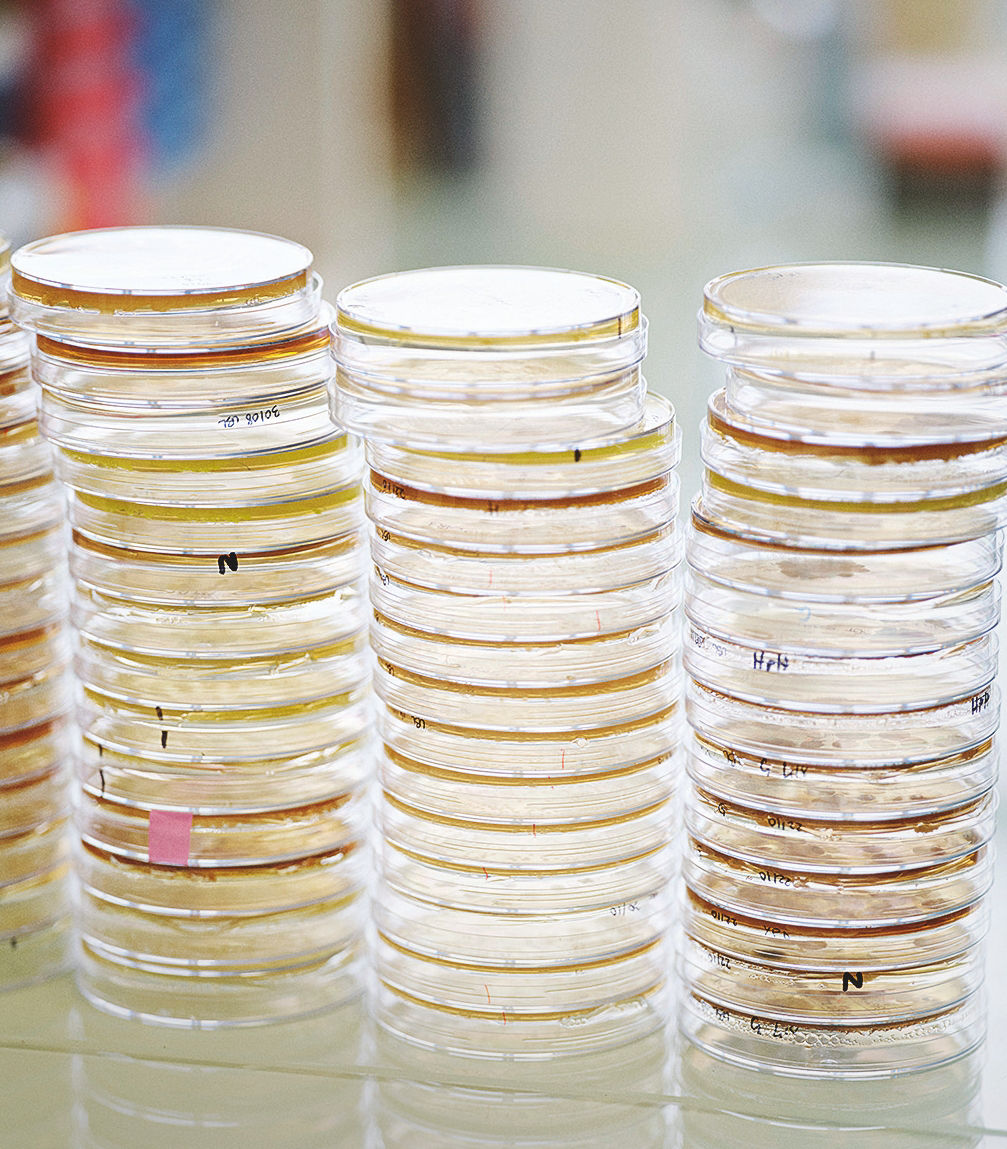
Drei Stapel mit jeweils etwa 15 Petrischalen stehen nebeneinander.

Knapp eine Stunde dauert die Fahrt aus Paris Richtung Süden, dann hält der Regionalzug am kleinen Bahnhof Le Bras de Fer. Wer hier aussteigt, wird von plakatgroßen Fotos mit Laborszenen begrüßt, die ankündigen, was fußläufig erreichbar ist: der Biotechnologiepark Genopole. 65 Unternehmen sind dort ansässig, eines davon ist Abolis. Die Gründer Valérie Brunel und Cyrille Pauthenier empfangen Gäste in ihrem Büro. „Es ist noch recht karg hier“, entschuldigt sich Pauthenier, „diesen Trakt haben wir erst vor einigen Wochen angemietet.“

»Abolis soll dazu beitragen, die Bedürfnisse unserer Gesellschaft zu befriedigen, ohne die Zukunft unserer Gesellschaft zu gefährden.«
Cyrille Pauthenier Co-Gründer und CEO von Abolis
Das Ziel: die Chemiebranche nachhaltiger machen
55 Beschäftige arbeiten derzeit bei Abolis, im Laufe dieses Jahres soll sich diese Zahl verdoppeln. Die Biologinnen und Softwareingenieure, Expertinnen für Robotik und Fermentation, Bioinformatiker und IT-Profis haben ein Ziel: Sie wollen der Chemiebranche mit biobasierten Inhaltsstoffen helfen, nachhaltiger zu werden – indem sie Mikroorganismen dazu bringen, Stoffe zu produzieren, die sonst viel aufwendiger gewonnen werden müssten. „Abolis soll dazu beitragen, die Bedürfnisse unserer Gesellschaft zu befriedigen, ohne die Zukunft unserer Gesellschaft zu gefährden“, fasst Pauthenier die Vision seines Unternehmens zusammen.
Um dieser Vision ein Stück näher zu kommen, ist das Unternehmen eine strategische Partnerschaft mit dem Kosmetikhersteller L’Oréal und mit Evonik eingegangen. Maßgeblich vorangetrieben hat das Projekt Thomas Satzinger, der bei Evonik die strategische Ausrichtung des Geschäfts mit Pflegemitteln und Inhaltsstoffen für Kosmetika verantwortet. „Wir haben ambitionierte Ziele bei der Transformation unseres Portfolios: Wir wollen den Anteil unserer Spezialitäten erhöhen und zugleich nachhaltiger werden.“ Dabei spielten biologisch gewonnene Rohstoffe, die zum Beispiel weniger Agrarfläche benötigen, eine entscheidende Rolle. „Abolis mit seinen biobasierten Produkten passte da perfekt.“


»Wir haben ambitionierte Ziele: Wir wollen den Anteil unserer Spezialitäten erhöhen und zugleich nachhaltiger werden.«
Thomas Satzinger Leiter Strategie Evonik Care Solutions
Abolis kann die Forschung an und die Entwicklung von innovativen Biomanufacturing- und Mikrobiom-Lösungen beschleunigen - dank des Investments eines internationalen Konsortiums im vergangenen Juli, dem unter anderem der Venture-Capital-Fonds von L’Oréal BOLD, der DeepTech & Climate Fonds und Evonik Venture Capital angehören.
Nachhaltigkeit betrifft auch in der Kosmetikbranche viel mehr als nur den CO2-Ausstoß. Um Shampoo, Make-up oder Hautpflegeprodukte ressourcenschonender und umweltverträglicher zu machen, müssen Hersteller die Auswahl der Rohstoffe ebenso in den Blick nehmen wie die Formulierung der Produkte und schließlich deren Anwendung im Badezimmer der Verbraucher. Die Kosmetikindustrie hat sich der Verbesserung ihrer gesamten Wertschöpfungskette angenommen. Schlüsselthemen sind etwa die fortschreitende Umwandlung von ökologisch wertvollen Flächen, die Art der Bewirtschaftung und faire Arbeitsbedingungen in der Landwirtschaft.
Strengere Vorgaben, mehr Nachfrage
Die effiziente Nutzung von Rohstoffen bei der Herstellung von Kosmetika ist ebenso wichtig wie die biologische Abbaubarkeit der kosmetischen Mittel selbst. Mit innovativen Ökodesign-Prinzipien arbeiten die Hersteller daran, die Produktnutzung durch die Verbraucher zu optimieren und den Verbrauch von Verpackungsmaterial und Energie zu reduzieren.
Für immer mehr Verbraucher spielt die Nachhaltigkeit von Kosmetikprodukten eine wichtige Rolle. Das Analyseunternehmen Straits Research schätzte das Volumen des Markts für biobasierte Kosmetik- und Körperpflegezutaten 2023 auf mehr als 5,2 Milliarden US-Dollar. Bis 2032 soll es auf mehr als 8,6 Milliarden US-Dollar anwachsen. „Die gesetzlichen Vorgaben sind strenger geworden, und auch unsere Kunden wählen Inhaltsstoffe zunehmend nach ökologischen Kriterien aus“, sagt Satzinger. Seit mehreren Jahren stellt Evonik kosmetische Öle mithilfe von Enzymen her, um so zur Reduktion der Emissionen von Kosmetika beizutragen. „Anfangs wollten nur wenige diese Öle haben. Heute sind sie sehr gefragt.“ Der überwiegende Teil der Inhaltsstoffe für Kosmetika, die Evonik produziert, sei mittlerweile biologisch abbaubar, so der Wirtschaftsingenieur. „Neue Produkte müssen dieses Kriterium von vornherein erfüllen.“
Auch die Leistung muss stimmen
Der verantwortungsvolle Umgang mit wertvollen pflanzlichen Ressourcen und deren umweltschonende Verarbeitung allein reiche aber nicht, betont Satzinger: „Auch die Leistung eines Produkts muss stimmen.“ Bestes Beispiel dafür sind Glykolipide, zu denen auch Rhamnolipide gehören. Diese Biotenside sind zugleich hautfreundlich und reinigungsstark als auch biologisch besonders gut abbaubar. 2024 lief die Rhamnolipidproduktion in einer neuen Anlage in der Slowakei an, was Evonik zum weltweit ersten Unternehmen machte, das Biotenside im industriellen Maßstab herstellt – ein Meilenstein auf dem Weg zu mehr Nachhaltigkeit.
Nicht alle Prozesse entwickelt Evonik allein. Wo es sinnvoll erscheint, investiert der Konzern in Unternehmen, die auf ihren jeweiligen Gebieten Expertenwissen gesammelt haben. Rund ein Dutzend Firmen erweitern so das Portfolio an Lösungen (siehe Info unten): Dr. Straetmans aus Hamburg etwa bringt Konservierungsexpertise ein, Botanica aus der Schweiz und Novachem aus Argentinien steuern Pflanzenextrakte bei.


Anfangs nur Werkbank und Pipetten
Einen weiteren Schritt nach vorn könnte nun die Zusammenarbeit zwischen Abolis, Evonik und L’Oréal bringen. Die drei Partner wollen Inhaltsstoffe in Zukunft biotechnologisch herstellen. Wie das Zusammenwirken aussehen soll, erklärt Thomas Satzinger so: „Benötigt L’Oréal für ein Produkt einen Inhaltsstoff, entwickelt Abolis eine biotechnologische Lösung im Labor. Funktioniert der Prozess im Kleinen, übernimmt Evonik – und überträgt ihn auf größeren Anlagen in die industrielle Herstellung.“
Mit der biobasierten Produktion von Molekülen kennen sich die Gründer von Abolis aus: Valérie Brunel, 54, ist Chemikerin und Expertin für Innovationsmanagement, Cyrille Pauthenier, 36, Chemiker und Biologe. „Wir lernten uns 2013 kennen, als Cyrille ein ambitionierter junger Forscher mit Unternehmergeist und Abolis nicht mehr als eine Powerpoint-Präsentation war“, berichtet Brunel. Dass sich Abolis dem Forschungscampus von Genopole anschloss, erleichterte den Start: „Wir hatten anfangs nur eine Werkbank, ein Büro und einen Satz Pipetten. Viele superteure Geräte, die wir benötigten, konnten wir uns hier zusammenleihen“, so die Chemikerin.
In den ersten zehn Jahren, sagt Brunel, hätten sie nur eine Million Euro aufgebracht, „was für ein Biotech-Unternehmen nicht viel ist“. Der französische Staat, der heimische Start-ups unterstützt, gab Starthilfe in Form von Zuschüssen. „Doch wir hatten von Anfang an Umsatz und haben es geschafft, das Unternehmen mit so wenig Ausgaben wie möglich zu führen.“ Dass sie Geräte leasen konnten, hätte ebenfalls geholfen. Schon nach wenigen Jahren entstanden die ersten Kooperationen mit großen Unternehmen, etwa dem Käsehersteller Bel, dem Lebensmittelkonzern Lesaffre oder eben 2019 L’Oréal.
Hefen übernehmen die Produktion
Mittlerweile verfügt Abolis über eigenes Equipment. Und das, erzählt Pauthenier, sei einer von vier Schätzen seines Unternehmens – „neben den Daten, den Mitarbeitenden und unseren Hefestämmen“. Deren Genom wird bei Abolis so verändert, dass sie aus einfachen Ausgangsstoffen wie Zucker ein gewünschtes Produkt herstellen. Der Prozess ähnelt dem Bierbrauen, bei dem Hefe durch Gärung Malzzucker in Alkohol verwandelt – nur dass die Hefepilze bei Abolis darauf programmiert werden, andere Stoffe herzustellen.
Hefe-Gentechnik sei die Kernkompetenz von Abolis, sagen die Gründer. Sie betonen jedoch, dass sie keine neuen Wirkstoffe entdecken, sondern lediglich neue Wege finden, um bereits bekannte Moleküle ressourcenschonender zu produzieren oder neue Moleküle zu entwickeln, die nur auf biotechnologischem Weg erzeugt werden können. „Manchmal interessiert sich die Kosmetikbranche zum Beispiel für einen Stoff, der nur in winzigen Mengen in einer bestimmten Pflanze steckt“, erzählt Pauthenier. „Millionen Tonnen davon für die Industrie anzubauen und das Molekül daraus zu extrahieren, ist ökologisch nicht sinnvoll – und praktisch oftmals unmöglich. Wir können jedoch eine Methode entwickeln, um es mithilfe unserer Hefen mit geringerem Flächenbedarf herzustellen. So erwecken wir auch Wirkstoffe zum Leben, die sonst nicht im großen Maßstab hätten produziert werden können.“ Die biotechnologische Produktion kann die chemische ersetzen, fossile Quellen oder seltene Ressourcen schonen – und ist dabei laut Pauthenier stabiler und leichter skalierbar als das natürliche Pflanzenwachstum.
Ein weiter Weg
Bis die Hefen produzieren, was sie sollen, ist es allerdings ein weiter Weg. Seinen Anfang nimmt er in der Abteilung für Informatik und Modellierung von Abolis. Hier entwickeln Ingenieure Sequenzierungssoftware, pflegen die Datenbanken, kontrollieren die Roboter im Labor und sichern die Genomdaten. Jede Menge Unwägbarkeiten müssen die Experten im Blick haben; zum Beispiel dass sich die Hefen nicht selbst mit dem Produkt vergiften, das sie herstellen. Hält Abolis die Produktion eines Stoffs durch einen Stamm für machbar, setzen Mitarbeiter im Labor um, was die IT-Fachleute zuvor berechnet haben.
Kolben mit blauen Deckeln und gelblich-klarer Flüssigkeit kreisen hier in Schüttelinkubatoren, Zentrifugenröhrchen stehen geordnet auf den Werkbänken, daneben stapeln sich Platten mit Nährmedien. Eine Mitarbeiterin in weißem Kittel und mit Handschuhen pipettiert sorgsam eine klare Flüssigkeit in kleine Reaktionsgefäße mit Plastikdeckel. Es sieht aus wie in einem klassischen Biotechnologielabor. „Der Unterschied steckt in diesen Tubes“, sagt Abolis-Mitgründer Pauthenier und zeigt auf die Flüssigkeit in den Reaktionsgefäßen.

Bis zu 600 Proben am Tag
Als Nächstes folgt ein Raum, der konstant auf 19 Grad Celsius temperiert ist. Mehrere Hochdurchsatz-Massenspektrometer analysieren gleichzeitig Proben, und eine automatische Pipettier- und Probenverarbeitungsstation verrichtet ihre Arbeit. „Hier entscheidet sich, ob ein Hefestamm aus dem Labor gut genug ist, um in unserer Fermentation weiterverfolgt zu werden“, erklärt Pauthenier.
Eine Etage tiefer stehen drei Roboter in einem lichtdurchfluteten Raum: Einer kann voll automatisch bis zu 96 Proben gleichzeitig verdünnen – viel schneller und präziser als ein Mensch. Ein zweiter isoliert und reinigt DNA. An einem Arbeitstag schafft er bis zu 600 Proben und verbraucht dabei besonders wenig Einwegmaterial wie etwa Pipettenspitzen. Ein dritter ist schließlich unter anderem darauf spezialisiert, Reagenzien auf Platten zu verteilen. „Ein paar Roboter zu kaufen, geht schnell“, sagt Pauthenier. „Aber sie so zu programmieren, dass sie laufen, wie sie sollen, dauert Jahre.“ Eine Aufgabe, die bei Abolis die IT-Experten übernehmen.
Einer dieser Experten arbeitet gerade mit seinem Laptop neben dem neuesten Gerät: Hinter einer Glasscheibe bewegt ein Greifarm Reagenzgefäße hin und her. Der Apparat hat rund 350.000 Euro gekostet und soll in Zukunft die Hefestämme kategorisieren. Robotik und künstliche Intelligenz betrachtet der Abolis-Chef als wertvolle Ergänzung der Fähigkeiten seines Teams, nicht mehr und nicht weniger. „Menschliche Kreativität und Intuition können sie nicht ersetzen.“

»Mit L’Oréal und Evonik können wir die gesamte Wertschöpfungskette abdecken.«
Valérie Brunel Co-Gründerin und Geschäftsführerin von Abolis
Mehr als die Summe der Teile
Die jüngst beschlossene Industriepartnerschaft bietet Abolis eine gewaltige Chance. Zwar arbeiten die Biotechnologiespezialisten aus dem Süden von Paris schon seit fünf Jahren mit den Forschern und Entwicklern des Kosmetikriesen L’Oréal zusammen. Die Dreierkonstellation mit Evonik jedoch bietet neue Möglichkeiten: „Zu dritt können wir die gesamte Wertschöpfungskette abdecken“, schwärmt Abolis-Mitgründerin Brunel. Vorher sei da immer diese Lücke gewesen: „Wir sprachen mit L’Oréal über neue Inhaltsstoffe, die wir aber gar nicht in großen Mengen produzieren können. Also haben wir Evonik als dritten Partner ins Boot geholt.“
Brunel und Pauthenier sehen in Evonik auch einen Pionier in der Mikrobiomforschung, insbesondere für die Tiergesundheit. „Das Tier-Mikrobiom ist ein Bereich, in dem auch wir gerade Know-how entwickeln, das die Arbeit von Evonik ergänzen könnte.“

Auch Guillaume Climeau, Leiter der Geschäftsentwicklung und des Allianzmanagements in der Forschung und Innovation von L’Oréal, verspricht sich viel von der Kooperation: „Abolis bringt das biotechnologische Fachwissen mit, wir kennen uns mit der Formulierung und den Verbrauchern aus, und Evonik verfügt über eine einzigartige Expertise, was die Industrialisierung der von Abolis entwickelten Prozesse angeht.“ Der Kosmetikkonzern will sein Portfolio um biobasierte Inhaltsstoffe erweitern und ist zuversichtlich, durch neue Formen der Zusammenarbeit schneller zu Ergebnissen zu kommen: „Wenn wir gemeinsam in einer kreativen Begegnung etwas aufbauen, ergibt eins plus eins plus eins mehr als drei“, sagt Climeau (hier geht es zum vollständigen Interview).
Geschaffen für Größeres
Was das bei der Zusammenarbeit im Forschungscampus Genopole bedeutet, zeigt Abolis-CEO Pauthenier an der letzten Station: dem Fermentationslabor. Hier treten die Hefen den Beweis an, dass sie auch Produktionsmengen von bis zu 20 Litern bewältigen. Ab dann übernimmt Evonik den Prozess und startet die Produktion mit den Hefen aus Frankreich in größeren Maßstäben.
Damit die Skalierung gelingt, haben die Experten aus dem Konzern schon den Entwicklungsprozess eng begleitet: „Die Ergebnisse einfach über den Zaun zu werfen, wenn die eine Seite fertig ist, funktioniert nicht“, stellt Thomas Satzinger klar.
ELEMENTS-Newsletter
Erhalten Sie spannende Einblicke in die Forschung von Evonik und deren gesellschaftliche Relevanz - ganz bequem per E-Mail.
„Wir sind von vornherein im Austausch mit Abolis, um frühzeitig zu erkennen, welche Weichen mit Blick auf einen optimalen Herstellungsprozess gestellt werden müssen.“ Wo Evonik produziert, hängt vom gewünschten Produkt ab – ein wichtiger Standort ist der Biotech-Hub im slowakischen Slovenská Ľupča mit seiner jahrzehntelangen Erfahrung in der Fermentation und dem Downstream-Prozess.
Lange wird es nicht mehr dauern, bis die ersten L’Oréal-Produkte mit biotechnologisch hergestellten Molekülen von Abolis und Evonik weltweit in den Verkaufsregalen stehen: „Ich erwarte, dass wir in wenigen Jahren die ersten Erfolge unserer Zusammenarbeit sehen“, sagt Satzinger. Abolis-Gründer Cyrille Pauthenier: „Etwas wissenschaftlich Spannendes und Herausforderndes zu tun, das wirtschaftlich und gesellschaftlich nützlich ist und noch dazu einen Beitrag für die Umwelt leistet, erfüllt mich.“ Global betrachtet sei Abolis vielleicht nur ein kleiner Stein, „doch auch kleine Steine können Großes ins Rollen bringen“.
Von pflanzenbasiertem Cholesterin zu alternativen Konservierungsmitteln
Wie Evonik durch Zukäufe von Unternehmen sein Know-how in der Biokosmetik stärkt. Eine Auswahl wichtiger Akquisitionen:
2017 – Dr. Straetmans: Norddeutsche Konservierungsideen
Konservierungsstoffe in Kosmetika schützen die Rezeptur und verringern das Risiko, dass sich Mikroorganismen in Cremes oder Lotionen vermehren. Ein Experte für alternative Konservierungssysteme ist das 1984 gegründete Hamburger Unternehmen Dr. Straetmans, das Evonik vor mehr als sieben Jahren gekauft hat, um seine Position in der Kosmetikindustrie auszubauen. Der Standort soll zum weltweit anerkannten Kompetenzzentrum für alternative Konservierungsmittel entwickelt werden. Diese erhalten anders als herkömmliche Mittel nicht nur die Qualität eines Produkts, sondern übernehmen auch weitere Funktionen und spenden zum Beispiel der Haut Feuchtigkeit. Der Einsatz dieser alternativen Konservierungssysteme ist komplex: Entsprechend hat die Erfahrung bei Dr. Straetmans auch die Formulierungskompetenz bei Evonik erweitert.
2020 – Wilshire Technologies: Phytochemie aus den USA
Was bei Wilshire Technologies erforscht und entwickelt wird, erweitert die Evonik-Palette an natürlichen Inhaltsstoffen erheblich: Sogenannte Phytochemikalien wie etwa pflanzliches Cholesterin oder ätherische Öle sind die Spezialität der 1997 gegründeten Biotechnologiefirma aus Princeton im US-Bundesstaat New Jersey. Wilshire Technologies hat sich in der „grünen“ Chemie einen Namen gemacht und produziert unter anderem bioaktive Inhaltsstoffe für die Pharma- und die Lebensmittelindustrie. Gründer Joe San Filippo war früher Chemieprofessor an der Rutgers-Universität in New Jersey.
2021 – Botanica: Schweizer Pflanzen-Know-how
Seit mehr als drei Jahren gehört Botanica zu Evonik. Die Schweizer Firma ist, wie die anderen genannten Spezialunternehmen, in die Business Line Care Solutions integriert. Botanica hat sich schon seit 1998 darauf spezialisiert, aus Blüten, Blättern, Knospen, Früchten, Wurzeln oder Rinde Inhaltsstoffe für die Körperpflegeindustrie zu ziehen – je nach Bedarf in Form von Extrakten, Tinkturen, Konzentraten oder Destillaten. Europaweit gelten die Schweizer als Marktführer in ihrem Segment. Das Sortiment des Unternehmens mit Sitz in Sins im Kanton Aargau besteht aus mehr als 1.000 Pflanzenrohstoffen, von Apfelminze bis Zeder, die das Wirkstoffportfolio von Evonik bereichern.
2021 – Infinitec Activos: Wirkstoffträgersysteme aus Spanien
Damit kosmetische Wirkstoffe an ihr Ziel gelangen, etwa in tiefere Hautschichten, können Wirkstoffträger als Transportmittel eingesetzt werden. Ein Spezialist für deren Entwicklung und Produktion ist die spanische Firma Infinitec Activos, die Evonik 2021 übernommen hat. Das Unternehmen erweitert das Wirkstoffträger-Geschäft von Evonik um sieben Systeme und mehrere natürliche Wirkstoffe. Hauptsitz von Infinitec Activos ist der Barcelona Science Park, ergänzt durch die Produktionsstätte in Montornès del Vallès und bei Naturethic, dem Produzenten der natürlichen Rohstoffe.
2023 – Novachem: Pflanzenextrakte aus Südamerika
Im Sommer 2023 hat Evonik Novachem übernommen, um das Portfolio pflanzenbasierter Inhaltsstoffe für Kosmetika zu erweitern. Das argentinische Unternehmen mit Sitz in Buenos Aires wurde 2007 gegründet und entwickelt für Evonik biotechnologische, natürliche und nachhaltige Wirkstoffe für Haut- und Haarpflegeprodukte. Dabei verwendet es Rohstoffe aus Lateinamerika, einer der artenreichsten Regionen der Welt. Novachem entwickelt umweltschonende Technologien und Verfahren in Kombination mit Feldprojekten, die die regionale Artenvielfalt schützen.


